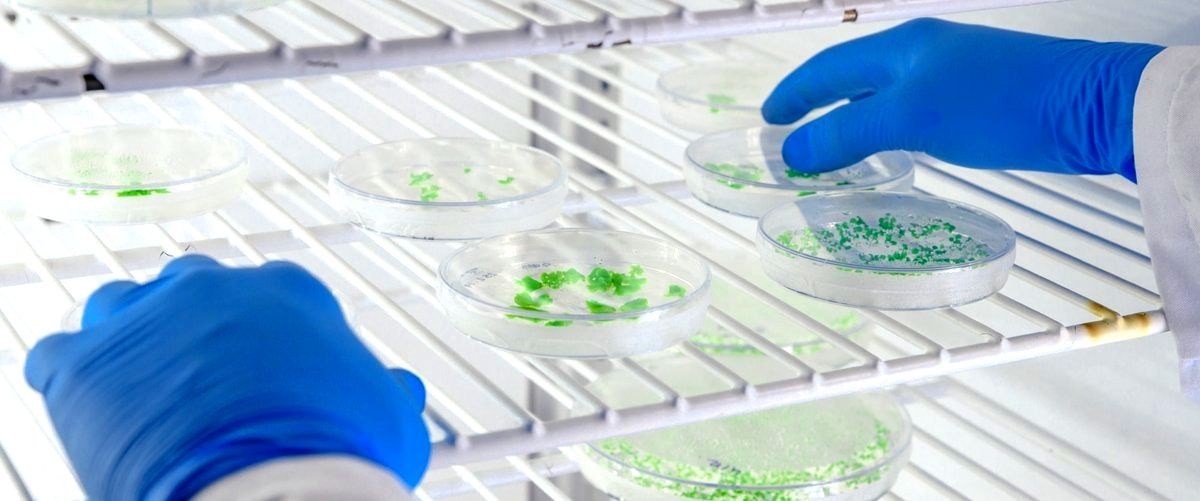
¿Qué productos fabrican las empresas químicas en Coruña (La Coruña)?

Si estás buscando las mejores empresas químicas en Coruña (La Coruña), has llegado al lugar indicado. En esta guía, te presentaremos una selección de las 11 mejores compañías del sector en esta ciudad gallega. Estas empresas se destacan por su calidad, experiencia y compromiso con el medio ambiente. Ya sea que necesites productos químicos para la industria, la agricultura o el hogar, encontrarás opciones que se ajusten a tus necesidades. ¡Sigue leyendo para descubrir las mejores empresas químicas en Coruña (La Coruña)!
Mejores Empresas Químicas en Coruña
1. Proquides: Proveedor de productos de limpieza en A Coruña
Pocomaco Av 5, Nº48 15190 A Coruña
PROQUIDES es un proveedor de productos de limpieza ubicado en el Polígono de Pocomaco, en la provincia de La Coruña. Con una puntuación perfecta de 5/5, PROQUIDES se destaca por ofrecer una amplia gama de productos de alta calidad para satisfacer las necesidades de limpieza de sus clientes. Ya sea...
2. Arteixo Química: Fábrica en Arteixo
Travesia Sabon, 51 15141 Arteixo
Arteixo Química SLU es un reconocido fabricante de productos químicos con sede en Arteixo, A Coruña. Con una puntuación de 4,8/5, esta empresa destaca por su excelencia en la calidad de sus productos y servicios. Su fábrica, ubicada en Travesia Sabon, 51, es un referente en el sector químico en...
3. Suministros J.L.V.: Proveedor de productos de limpieza en A Coruña
Labañou, Rúa Pintor Francisco Llorens, 10 15011 A Coruña
Suministros J.L.V. es una empresa proveedora de productos de limpieza en A Coruña. Con una puntuación de 5/5, se ha destacado por ofrecer soluciones para cubrir las necesidades de diferentes sectores como la hostelería, la automoción y la industria en general. Además de ser una empresa de suministros industriales, también...
4. Fresh & Clean: Proveedor de productos de limpieza en A Coruña
Rúa Gambrinus, 44 15008 A Coruña
Fresh & Clean es una empresa que se dedica a proveer productos de limpieza de alta calidad. Con una puntuación perfecta de 5/5, Fresh & Clean se ha ganado la confianza de sus clientes en la ciudad de A Coruña. Su compromiso con la excelencia y la satisfacción del cliente...
5. Würth: Empresa de suministros industriales en A Coruña
Avda. Principal, parcela B-3 Módulo C 15190 A Coruña
Autoservicio Würth A Coruña es una empresa de suministros industriales ubicada en el Polígono de Pocomaco, en la provincia de La Coruña. Con una puntuación de 4,6/5, esta empresa se destaca por su amplio catálogo de productos y su excelente servicio al cliente. Su compromiso con la calidad y la...
6. DE ECO: Proveedor de productos de limpieza en A Coruña
Rúa Manuel Deschamps, 29 15011 A Coruña
DE ECO Productos de Limpieza es un proveedor de productos de limpieza ubicado en A Coruña. Con una puntuación de 4,8/5, esta empresa ofrece una amplia variedad de productos para la limpieza en diferentes sectores como el sanitario, la hostelería, las colectividades y las empresas de limpieza. Además, DE ECO...
7. Repsol: Refinería de petróleo en A Coruña
15008 A Coruña
La Refinería de Repsol, ubicada entre los municipios de Arteijo y La Coruña, es una importante infraestructura petrolífera en España. Con una capacidad de refino de 120,000 barriles por día y una extensión de aproximadamente 150 hectáreas, esta refinería es propiedad de Repsol, una empresa con sede en Madrid. Aunque...
8. Ecousos: Proveedor de productos de limpieza en Polígono de Pocomaco
Parcela G23 15190 Polígono de Pocomaco
Ecousos | Sostenibilidad y Eficacia | Celulosa, Productos de Limpieza, Packaging es un proveedor de productos de limpieza ubicado en el Polígono de Pocomaco, en la provincia de La Coruña. Con una puntuación de 5/5, la empresa se destaca por su enfoque en la sostenibilidad y eficacia en la distribución...
9. 3C Calidad y Control S. Coop. Galega: Laboratorio químico en Polígono de Pocomaco
Calle 1, G12/2 15190 Polígono de Pocomaco
3C CALIDAD Y CONTROL S.COOP.GALEGA es un laboratorio químico ubicado en el Polígono de Pocomaco en La Coruña. Con una puntuación perfecta de 5/5, la empresa se destaca por ofrecer servicios de control de calidad en la construcción a través de análisis físicos, mecánicos y químicos. Su compromiso con la...
10. Suquicel: Proveedor de productos de limpieza en Polígono de Pocomaco
Polígono de Pocomaco Calle nº2 Parcela F10-2 Polígono de Pocomaco
Suquicel es un proveedor de productos de limpieza ubicado en el Polígono de Pocomaco, en A Coruña. Con una puntuación de 5/5, Suquicel se destaca por ofrecer una amplia gama de productos de alta calidad para la limpieza y el mantenimiento de hogares, oficinas y otros espacios comerciales. Su ubicación...
11. Voxquimia: Industria química en A Coruña
Estrada Nostián, 8 15008 A Coruña
Voxquimia es una empresa de Industria química ubicada en 15008 A Coruña. Con una puntuación de 1/5, la empresa ofrece una variedad de servicios relacionados con la industria química. A pesar de su baja calificación, Voxquimia se dedica a brindar soluciones químicas a sus clientes, utilizando su experiencia y conocimientos...